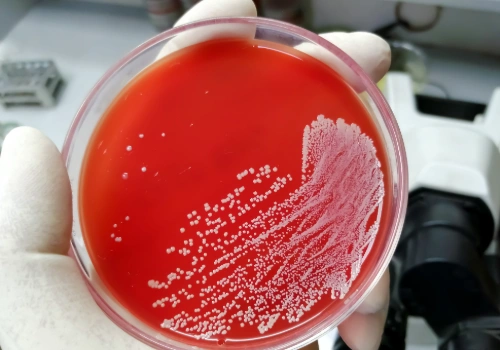
Petri dish showing Staphylococcus aureus (staph) bacterial growth

Neurology
Why Do My Hands Shake? Is It Too Much Caffeine or Something Neurological?
Hand tremors can be caused by caffeine, stress, or neurological conditions. Learn common causes and when to seek medical evaluation.
Learn MoreFeatured Posts


Current Events
January 7, 2026
Understanding the 2026 CDC Childhood Vaccine Schedule: A Pediatrician’s Perspective


Recent Posts
.png)
Knowledge
|
June 9, 2025
Summer Food Safety 101: How to Prevent Food Poisoning at Your Next BBQ
Grilling this summer? Learn how to avoid foodborne illnesses like salmonella and E. coli with these simple tips for cooking, chilling, and storing food safely outdoors.
.png)
Primary Care
|
June 7, 2025
Swimmer’s Ear: Causes, Symptoms, and When to See a Doctor
Is your child complaining of ear pain after swimming? It might be swimmer’s ear. Learn the causes, signs, and when to see a doctor. BASS Medical Group offers fast relief.
Knowledge
|
June 6, 2025
Staph Infections: When Is That Skin Bump Something to Worry About?
Is that red bump on your skin a staph infection? Learn about symptoms, treatment, and how to tell if it's something more serious like MRSA. Get care at BASS Medical Group.
.png)
Primary Care
|
June 5, 2025
Hay Fever vs. Summer Cold: How to Tell the Difference
Is it hay fever or just a summer cold? Learn how to tell the difference between allergy symptoms and a viral cold—and when to see a BASS Primary Care doctor.

OB-GYN
|
June 3, 2025
Can a Pregnancy Test Be Wrong? Understanding False Positives and False Negatives
Wondering if your pregnancy test result is accurate? Learn what causes false positives or negatives and when to follow up with your doctor at BASS Medical Group.

Neurology
|
June 2, 2025
Dementia vs. Alzheimer’s: What’s the Difference?
Wondering if dementia and Alzheimer’s are the same thing? Learn how they differ, what symptoms to look for, and how BASS Medical Group can help with memory care.

Health Tips
|
June 1, 2025
Summer Travel Health Guide: What to Know Before You Go
Traveling this summer? Learn how to prevent illness, prepare for international trips, protect kids from heat exhaustion, and stay safe in the air. BASS Medical Group offers expert advice.

OB-GYN
|
May 28, 2025
5 Screenings Every Woman Should Have to Stay Healthy at Every Age
From breast cancer and heart screenings to bone density and mental wellness—here are 5 essential health screenings every woman should consider at every stage of life.
.png)
Cancer
|
May 27, 2025
How to Spot Skin Cancer Early: The ABCDE Rule Explained
Learn how to recognize early signs of skin cancer using the ABCDE rule. Know when to see a doctor and protect your skin with expert care from BASS Cancer Center.

Community
|
May 24, 2025
Honoring Veterans This Memorial Day: Community Health & Support Resources in Walnut Creek
This Memorial Day, explore trusted veteran health and support resources in Walnut Creek and Contra Costa County, including VA services, counseling, and community assistance programs.

Knowledge
|
May 22, 2025
FDA’s New COVID Vaccine Policy: Who Can Still Get a Booster in 2025?
A new 2025 FDA policy limits COVID-19 booster shots to high-risk groups. Learn if you still qualify and how BASS Primary Care can help you prepare for fall vaccination.
.png)
Cancer
|
May 21, 2025
Exercise and Cancer Treatment: How Movement Can Reduce Side Effects and Improve Recovery
A major study shows that aerobic, strength, and yoga-based exercise can reduce cancer treatment side effects like fatigue, brain fog, and heart damage. Learn how patients at the Gregory Rhodes MD Cancer Center can benefit.

Gastroenterology
|
May 19, 2025
Sick to Your Stomach in the Morning? Possible Causes
Feeling sick to your stomach in the morning? Learn the possible causes of morning nausea and when to see a doctor. BASS Medical Group explains what to watch for.

Exercise
|
May 19, 2025
How to Stay Active at a Desk Job: Fitness Tips for 9–5 Workers
Sitting all day? Learn simple ways to stay active at your 9–5 job with quick workouts, posture tips, and wellness strategies from BASS Medical Group.

Lifestyle
|
May 15, 2025
Surprisingly High-Sodium Foods — and Healthier Swaps for a Heart-Healthy Diet
Too much salt raises blood pressure and heart disease risk. Learn about hidden high-sodium foods — and discover simple, healthy swaps from the experts at BASS Medical Group.

Cancer
|
May 12, 2025
Can You Get Sunburned on a Cloudy Day? (And Other Sun Protection Myths)
Yes, you can get sunburned on cloudy days. Learn the truth about UV rays, sunscreen, and skin protection from the experts at BASS Cancer Center.

OB-GYN
|
May 9, 2025
Moms, Don’t Forget to Care for Yourself This Mother’s Day
This Mother’s Day, BASS Medical Group encourages women to prioritize their own wellness. Discover how OB/GYN and primary care visits can support your long-term health.
.png)
Lifestyle
|
May 8, 2025
High Blood Pressure Doesn’t Always Show Symptoms — But the Damage Can Be Serious
High blood pressure often has no symptoms until it leads to heart disease, stroke, or kidney damage. Learn the risks and how to stay ahead of hypertension with BASS.

Community
|
May 6, 2025
National Nurses Day: Celebrating the Nurses Who Power Patient Care
In honor of National Nurses Day, we celebrate the nurses at BASS Medical Group who provide compassionate, expert care every day.
.png)
Cancer
|
May 5, 2025
Skin Cancer Awareness Month: How to Spot the Signs and Protect Your Skin
May is Skin Cancer Awareness Month. Learn how to recognize early signs of skin cancer and how to protect your skin with tips from BASS Cancer Center.
